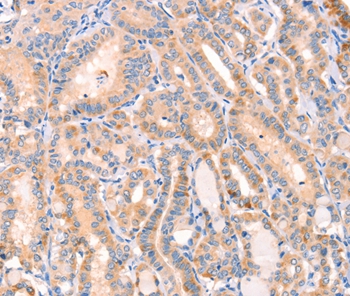

Anti-CD109 Antibody
A46135
ApplicationsImmunoHistoChemistry
Product group Antibodies
Overview
- SupplierAntibodies.com
- Product NameAnti-CD109 Antibody
- Delivery Days Customer7
- ApplicationsImmunoHistoChemistry
- CertificationResearch Use Only
- ClonalityPolyclonal
- Concentration1.1 mg/ml
- ConjugateUnconjugated
- HostRabbit
- Scientific DescriptionRabbit polyclonal antibody to CD109
- UNSPSC12352203

![WB analysis of various samples using GTX04726 CD109 antibody [ARC61642]. NC : negative control Loading : 25 microg Dilution : 1:1000](https://www.genetex.com/upload/website/prouct_img/normal/GTX04726/GTX04726_20240130_WB_1_24012922_438.webp)
